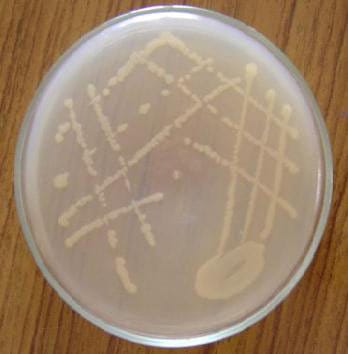

This certainly looks interesting. You need to watch to the very end of this 1:15 long trailer. There’s NSFW language in this and until you hear “Oh… shitballs!” you’ve not got to the end. Oh, if you’re a Harry Potter insaner then the opening quote my displease you. This a project from the Strong Brothers. […]
Archives for March 2011
Dragon Age Malevolence trailer
Dragon Age: Malevolence is a fan-made short film. No, it’s not the Felicia Day effort, it’s another one. The director is Leo Kei Angelos, and he describes himself as a true Dragon Age fan. What’s the budget? It’s pegged at about $0,000.00. I’d say the costumes look pretty impressive. Perhaps they’re LARPers! What do you […]
Lion-o plushie is king of cute
Chelsea Bloxson needs to be recognised as the creative talent she is. Not only is this plushie Lion-o incredibly cute it’s very detailed too. The arms are jointed and the Sword of Omen is attached via velcro. Thundercats, hooooaaah!
The Dead Space beacon… in lego
There’s a lot of things you can build with Lego with lots of skill and a bit of imagination. With enough imagination you might even decide to build a Dead Space beacon. Perhaps the frustration of planting beacons in asteroids boiled over and you just had to turn to lego. We can’t know Legohaulic‘s motivation […]
Buy your very own Romulan Ale Star Trek energy drink
Heads up folks – this isn’t booze – this Romulan Ale is actually a caffeine packed energy drink. Oh – and Think Geek can’t ship it out of the States or Canada. Not sure whether that’s due to the faff of shipping food around, the EU having a different view of what a wise amount […]
Poke-Rights – Poke-Fights are wrong!
This video shines the light on the evil and cruel world of Pokemon fighting. You might try and pretend your Pokemon is not a slave but then why is role the master? Will it only stop when they’ve all been caught. Watch this video and consider your position on this barbaric hobby. If you’ve been […]
World’s first synethetic life form receives cease and desist letter
In 2010 the famous geneticist J. Craig Venter created the first ever synthetic life form. Venter and his team modified a version of the bacteria Mycoplasma capricolum by creating their own genetic code synethetically and inserting it. The result, because of the replaced DNA, was an entirely new bacteria called Mycoplasma mycoides. The thing is, […]
Skeleton Silverware: Not werewolf friendly
SIlver skeleton cutlery
Captain America: The First Avenger trailer
We’ve had clips and sneaky stills smuggled from teasers for the Captain America: The First Avenger movie for a while now. We’ve not had a full trailer. Until now. Got to say; the computer wizard who “de-buffs” Chris Evans is very good at their job. I wonder how much of the movie will focus on […]
Tiny Doctor Who teaser videos
Season 6 of new Doctor Who is nearly here. Well. It’s closer than ever before and the evil BBC are teasing us with some tiny trailer videos. There are two of them. The first is the teaser to the prequel. The prequel is a web-based release that’ll appear on the BBC Doctor Who site at […]